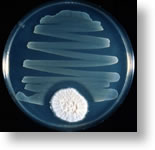

|
Correct, that's Penicillin! In the late 1800s, when it was generally accepted that germs (bacteria and microbes) were causing diseases, the search for antibiotics began. These were compounds that would destroy microbes without causing harm to the body. In 1929, Alexander Fleming, a bacteriologist working at St. Mary's Hospital in London, discovered penicillin. He isolated the compound from a mold that repressed bacterial growth. Penicillin is now one of the most widely used antibiotic agents. It inhibits formation of cell walls, thereby, making cells structurally weak.
|